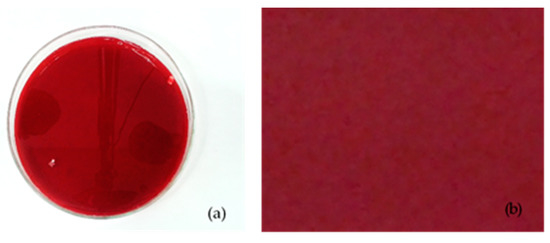

Abstract
Two pomegranate cultivars, Mollar de Elche, native to Spain, and Wonderful, the most widely cultivated pomegranate variety in the world, were studied in a commercial orchard in Sicily, and their phenological behavior was compared. During the development of the fruit, their dimensional growth was monitored, and after harvest, physicochemical and sensory analyses were carried out to highlight the differences between fruit of the two cultivars. Results showed that Mollar de Elche fruit require less time from flowering to fruit maturity, resulting in an earlier harvest, which was due also to a higher relative growth rate of the fruit’s diameters. On the other hand, physicochemical analyses confirmed that Wonderful is the variety that is most appealing for fresh produce consumers due to its intense coloring. However, Mollar de Elche showed economically desirable characteristics such as a good softness of the seed. Moreover, sensory analysis showed that fruit of the cv. Mollar de Elche was found to have a sweeter taste of both arils and juice.
1. Introduction
Pomegranate (Punica granatum L.) is an ancient deciduous tree crop that has been domesticated for thousands of years and offers a broad range of varieties and consumption opportunities for the consumers [1,2,3].
It is native to the region extending from Iran to the Himalayas in northern India, and Mediterranean and Middle-East countries are currently the main regions of pomegranate cultivation and production [4,5].
According to Levin [6], there are three large centers (primary, secondary, and tertiary) and five macro centers (Middle Eastern, Mediterranean, Eastern Asia, American, and South African) of origin and genetic diversity of the pomegranate. It is a temperate species that requires high summer temperatures to ripen properly. For this reason, its cultivation is relegated to the Mediterranean basin, southern Asia, and several countries of North and South America. Its adaptation to the Mediterranean climate has led to its wide diffusion and the creation of a multitude of new genetic individuals over time.
As a result of the low levels of respiration and ethylene products, the pomegranate is considered a non-climacteric fruit [7]. Pomegranate fruit maturity status is commonly assessed based on skin color and juice color and acidity [8]. The acceptability of pomegranate by the consumer depends on a combination of several quality attributes that are related to the physicochemical and mechanical properties including skin color, absence of physical defects, sugar content, acidity, and flavor [9]. Sweet and sweet–sour cultivars were liked better than sour cultivars, which can be described as having over 1.85% titratable acidity in citric acid equivalents (TA) at maturity. They also found that sweetness and sourness were not the only important determining factors but that low to moderate acidity and seed softness were also determining factors for consumer preference [10]. Martinez et al. [11] found that cultivars can have high variability for seed hardness, sugar content, acidity, maturity index, and several other variables important to both growers and consumers, including bitterness.
Pomegranate fruit is consumed directly as fresh arils as well as fresh juice; it is also used extensively in the food and beverage industry as a flavoring and coloring agent as well as gelling agent [9].
The arils are considered a functional product of great benefit in the human diet, as it contains several groups of compounds that are useful in disease prevention [12,13,14], reducing the risk of cardiovascular and other chronic disorders [15,16]. The beneficial health qualities have been attributed to the exceptionally high antioxidative capacity of the fruit juice [17], which is seemingly the result of the remarkably high content and unique composition of soluble phenolic compounds in a cultivar-dependent manner [17,18,19,20]. Various researchers have reported that the chemical composition of pomegranate arils differs depending on the cultivar, growing region, climate, maturity, harvest practices, and storage [21]. Furthermore, significant differences in sugars, water-soluble vitamins, and mineral composition have been reported over the years for the various cultivars [22,23,24]. Hence, it is essential to accurately recognize chemical–physical, sensory, and nutraceutical characteristics of the product to meet the current market demand for quality fruit [11]. Recent years have seen increased interest from the consumers, researchers, and the food industry into how food products can help maintain health, and the role that diet plays in the prevention and treatment of many illnesses has become widely accepted [25].
Pomegranate has been widely cultivated in Sicily for centuries [26], but it has suffered a significant reduction in dedicated hectares, although it also maintained its great importance as isolated plants in gardens and orchards. Its cultivation is based on numerous local ecotypes [26,27,28] that are currently flanked by new varieties from genetic improvement programs [29], constituting a wide range of fruit typologies that are very diversified in terms of commercial destination and quality for consumption [9].
Due to their physicochemical characteristics such as fruit weight, volume, and juice content, fruit obtained from traditional Sicilian varieties are hardly compatible with current market standards. In fact, these parameters are the ones that mostly influence consumers [30,31]. This had a significant impact on the fresh fruit market appeal of Sicilian pomegranate varieties, relegating them to a marginal role, since production of the old cultivars is exclusively sold on local markets, increasing the quantities of fruit imported from Spain that reach the Italian supermarkets [32].
The spread of world-class cultivars (Wonderful, Akko, Mollar de Elche, Hicaz, Bagua, and Parfianca) has been facilitated by the adoption of new agronomic techniques, which have improved both production efficiency and organoleptic qualities [20], to meet the needs of the market and consumer tastes, thus increasing consumption. These new varieties are encouraging the revival of pomegranate in Sicily as an income crop: many entrepreneurs, driven by the need to diversify their offer and expand their business, have identified in it a viable alternative to traditional orchards. Among the new varieties, “Mollar de Elche”, the most popular cultivar on the Spanish market, is particularly appreciated due to the intense sweetness and softness of its easy-to-chew arils [33].
The introduction of new varieties requires a study of their adaptation to climate traits. As in other temperate species, the pomegranate tree shows different phenological characteristics through its vegetative cycle in response to changing temperature [34]. It requires a certain amount of winter chilling to overcome their dormancy; once the chilling requirements have been satisfied, heat is also required to reach full bloom stage [35]. Melgarejo et al. [34] identified thirteen phenological stages during the annual cycle, starting at bud in winter dormancy and ending with leaf fall in Mollar de Elche pomegranate in Valencia (Spain) based on the BBCH (Biologische Bundesanstalt, Bundessortenamt and Chemical industry) General Scale developed by Bleiholder, Van den Boom, Langeluddeke, and Stauss [36] but, as of today, no studies were conducted on cv. Wonderful.
The goal of this work was to monitor the phenological evolution of Wonderful pomegranate comparing with Mollar de Elche in the growing environment of South Italy (Sicily), according to the BBCH scale and assess the quality attributes of these pomegranate varieties, which represent an innovation in terms of physiochemical characteristics and sensory profile compared to traditional ones, in order to evaluate their attitude to fresh consumption and fresh-cut produce or juice transformation.
2. Materials and Methods
The trial was carried out in a commercial orchard located in the territory of Camastra, in the province of Agrigento, Sicily (37°15′04″ N–13°47′39″ E), consisting of 12-year-old trees. The BBCH pomegranate phenological scale, defined by Melgarejo et al. [24], was taken into consideration to evaluate the growth of the fruit of the two cultivars in relation to climatic data. The latter were supplied by SIAS, Sicilian Agro-meteorological Service, taking as reference the telemetering station “Mandrascava” (40 m above sea level) located in the vicinity of the orchard.
According to the data provided by the weather station, the yearly average temperature in this area is 23.6 °C, and the average yearly rainfalls are of 647 mm, with 78 rainy days. Under the bioclimatic aspect, the zone is referred as belonging to the upper infra-Mediterranean lower sub-humid bioclimatic belt [37].
The following parameters were monitored to describe the growth environment of the selected varieties: rainfall (mm), daily minimum and maximum relative humidity (%), daily minimum and maximum temperatures (°C) (Figure 1).

Figure 1.
(a) Rain trend (mm); (b) relative minimum and maximum humidity (°C); (c) minimum and maximum temperatures (%). Values represented as monthly mean.
Data provided from SIAS showed that the period considered in this study (30 June–28 October 2014) was characterized by a reduced rainfall (only 4.8 mm in September) compared to the total 491.6 mm of the year, and an average temperature of 28.5 °C.
2.1. Plant Material
Fruit were harvested on different dates depending on the ripening times of the two varieties. Fruit of the cv. Mollar de Elche, the earliest variety, were harvested in the first decade of October, whereas fruit of the cv. Wonderful were picked in the third decade of October. The fruit were harvested at commercial maturity using the total soluble solids content (TSS)/TA ratio as harvest index [38]. The plants were trained to a vase shape, and both cultivars receive the same amount of inputs.
2.2. Experimental Design
Fifteen trees were selected for each variety, and the phenological stages were monitored for each plant, based on the pomegranate BBCH scale [34]. Ten fruit per plant were labeled, and their growth was evaluated by measuring the transverse diameter TD (mm) and the longitudinal diameter LD (mm) at two-week intervals using a digital caliper (TR53307, Turoni, Forlì, Italy), for a total of seven measurements over a three-month long period from July to October.
The relative growth rate (RGR; %) of the two diameters was obtained calculating the percentage variation of each reading compared to the previous one.
The Shape Index (SI; %) of the fruit, which is a measure of their sphericity, was calculated as LD/TD. The volumetric growth of the fruit throughout their development was also estimated, assuming the shape as spherical, calculating their volume as
where r was obtained as the half of the mean of the two diameters [39].
When ripening point was reached, the fruit were harvested and immediately submitted to the postharvest laboratory for physicochemical and sensory analysis. The same 10 fruit for each plant of both varieties were harvested for each plant, 100 of them were used for physical–chemical analysis and 50 were used for sensory analysis.
2.3. Physicochemical Analyses
For each fruit, length without calyx (longitudinal diameter—LD; mm) and equatorial width (transverse diameter—TD; mm) were measured with a digital caliper (TR53307, Turoni, Forlì, Italy). Fruit weight (FW) was measured with a digital scale with an accuracy to two decimal places (Gibertini EU-C 2002 RS, Novate Milanese, Italy).
For the color evaluation of fruit skin and the arils of each fruit, both were photographed with a DSLR camera (Figure 2 and Figure 3) and then the F.A.S. (Fruit Analysis System) software, based on a MATLAB 6.0 algorithm that converts images from the RGB format to the CIE format (L* = lightness, a* = green (−100) to red (+100), b* = blue (−100) to yellow (+100)) [29], was used on the photos. Then, it was possible to obtain Fruit Color Index (FCI) and Arils Color Index (ICA), which were calculated as the Color Index (CI) (using Equation (1)) [40] for the fruit skin and arils, respectively:

Figure 2.
Photos of the: (a) whole fruit; (b) fruit after peeling; (c) arils of Mollar de Elche cv.

Figure 3.
Photos of the: (a) whole fruit; (b) fruit after peeling; (c) arils of Wonderful cv.
The pixel ratio between the red-colored area and total fruit area was used to quantify the percentage of cover color (CC%) [41].
After the non-destructive analyses, the same fruit were opened with a curved knife, and the following determinations were carried out on each fruit: number of arils (NA); arils weight (WA; g); skin weight (SW = FW − WA; g); skin thickness (ST; mm); skin index (SkI = SW/FW × 100); skin thickness index (STI = ST/TD × 100); weight of 20 arils (WA20;g); arils height (AH; mm); arils width (AW; mm); arils yield (AY = FW − PW); weight of 20 seeds (SdW20; g); arils colour (ICA) and woody part index (WPI = SdW/WA × 100). Traits of the arils such as AH and AW were obtained as the means of readings on samples of 40 arils
A digital caliper (TR53307, Turoni, Forlì, Italy) was used for diameter and thickness measurements, and weight of the fruit and arils was determined using an electronic platform scale (Gibertini EU-C 2002 RS, Novate Milanese, Italy).
The juice of each fruit was obtained with a centrifugal juicer (Centrika Metal, Mod. 0173, Ariete, Italy) to obtain juice on which the following parameters were determined: juice content (JC; mL/100 g) determined with a graduated cylinder (500 mL), total soluble solids content (TSS; °Brix) determined using an Atago Pal-1 pocket refractometer (Atago Co., Ltd., Tokyo, Japan), titratable acidity (TA; g citric acid/L) determined with a Crison Compact titrator pH-meter (Crison Instruments, SA, Barcelona, Spain) with 0.1 N NaOH up to pH 8.1, and juice color index (JCI) by photographing the juice and then using the F.A.S. software (Figure 4 and Figure 5).
Figure 4.
(a) Juice extracted from the arils and put in a petri dish to be photographed; (b) sample of the juice color that was analyzed with the F.A.S. software of the variety Mollar de Elche.

Figure 5.
(a) Juice extracted from the arils and put in a petri dish to be photographed; (b) sample of the juice color that was analyzed with the F.A.S. software of the variety Wonderful.
2.4. Sensory Analysis
Twenty-five fruit of each variety were used to collect respectively 1500 g of arils, which were later subjected to evaluation by a panel of semi-experienced members. Twenty-five more fruit of each variety were used to collect 1000 mL of arils juice of each variety, on which a parallel sensory analysis was carried out on a single session.
So, each judge was provided with fifteen arils, which were divided in three replicates of five arils (for a total of about 40 g), of each variety and, later, with a sample of 40 mL of arils juice, divided in two replicates of 20 mL, of each variety.
The sensory profile (assessed according to UNI 10957:2003 legislation) was defined by a group of 30 judges, who were previously trained with four training sessions in the recognition of qualitative characteristics; they generated 11 descriptors for arils and 10 descriptors for juice at a preliminary meeting [20,42,43,44,45]. The following descriptors have been identified on the arils on the basis of the citation frequency (>60%) and listed below: two for the tactile ones (easy peeling and easy separation of the arils), one for the sight (color), two for the odor (odor of pomegranate and herbaceous), four for the taste (acid, sweet, bitter, astringent), and two for the flavor (flavor of pomegranate and herbaceous).
For the juice, the following descriptors were chosen: one for the sight (color), one for the rheology (density), two for the odor (odor of pomegranate and herbaceous), four for the taste (acid, sweet, bitter, astringent), and two for the flavor (flavor of pomegranate and herbaceous)
The judges evaluated the intensity of each attribute by assigning a score from 1 (no sensation) to 9 (maximum sensation intensity). The evaluation for arils and the one for juice were carried out at the sensory analysis laboratory, which was built according to UNI ISO 8589 legislation, equipped with a specific software for sensory data acquisition (FIZZ Biosystemes, Couternon, France). The assessments were carried out between 10 am and 12 pm in individual cabins. The order in which samples were presented was randomized between judges and sessions. Water was provided between samples to rinse the mouth. Thus, the obtained profile allowed quantifying the characteristics of the samples individually and in order of perception [46].
2.5. Statistical Analysis
Analysis of variance was applied to all the variables studied. The mean values obtained in the different categories were compared by one-way ANOVA, and significant differences among means at p < 0.05 were determined by Tukey’s test. All statistical analysis was conducted using SigmaPlot software version 12.0 (Systat Software, Inc., San Jose, CA, USA).
3. Results
3.1. Phenological Stages Evolution
Based on the BBCH scale by Melgarejo et al. [34], it was possible to keep track of the phenological evolution of the cv. Mollar de Elche and cv. Wonderful, cultivated in Sicily.
The prevailing phenological stages of the two cultivars are shown in the Figure 6. Both varieties stay in the same phenological stage, leaves growth stage (D3:11), from January to the first decade of April.

Figure 6.
Phenological stages observed on the two cultivars during the period of the study.
In the third decade of April, Wonderful is at the stage of elongation of the internodes (D4:31), while Mollar de Elche reached a more advanced stage (gem appearance—E:51). From the first decade of May until the first decade of July, both varieties continue to grow at the same rate and go from the stage E2:55 (swelling of the calyx) to the formation of the fruit (I:71). This last phase continues for Mollar de Elche until the third decade of July, when Wonderful is close to the fruit enlargement stage (J:73).
From the second decade of August to the second decade of September, the plants show a different evolution of the phenological phases: Mollar de Elche is in the second germination phase (K:39), while Wonderful is in the next fruit ripening phase (L:81.85) and that for Mollar de Elche will start only in the first decade of September. The ripening of the pomegranate fruit continues until the harvest, which is carried out first for Mollar de Elche (first decade of October) and then for Wonderful (third decade of October). From the third decade of November, in both varieties, foliage falls (M:39).
Both varieties showed a similar initial growth pattern, and instead, differences in the progress of phenological phases were found from the first decade of July to the first decade of September due to different ripening periods, as was seen in the work of Ikinci et al. [35].
In fact, it can be seen that flowers in Mollar de Elche appear (phenological stage E: appearance of the flower bud and calix) already at the end of April, while Wonderful reaches the same stage only at the middle of May.
Fruit of the cv. Mollar de Elche also require a shorter period to complete their growing: in fact, they enter the phenological stage “L” of fruit ripening on the 10th of September, and harvest begins on the 10th of October.
Instead, cv. Wonderful enters the same stage on the 20th of August and harvest only begins on the 30th of October. These results reflect what has been observed in various other cultivation areas [2], and this implies that fruit of cv. Mollar de Elche can be placed on the fresh fruit market two weeks ahead of those of the cv. Wonderful, giving growers the opportunity to obtain a more rewarding selling price.
The phenological stages of fruit set and fruit growth happen during the hot and dry summer season. During this time of the year, temperatures are favorable to the fruit growth [35], but at the same time, the water requirements of the trees are the highest. Therefore, it can be stated that the cultivation of pomegranate in Sicily cannot prescind from the use of irrigation, which also plays a fundamental role in obtaining quality fruit [2,47,48].
3.2. Fruit Dimensional Growth
Fruit growth, measured by means of the transversal and longitudinal diameters, is very similar between the two cultivars (Figure 7); both cultivars show the sigmoidal pattern typical of the species, described by Gozlekci and Kaynak [49].

Figure 7.
Time course of longitudinal (LD) and transverse (TD) diameters (mm) of the fruit of the cultivar Wonderful (a) and Mollar de Elche (b) and their relative growth rates (RGR). Diameters data are expressed as mean values ± SD.
In the first decade of July, cv. Wonderful has a transversal diameter of 53.00 mm and a longitudinal diameter of 58.39, whereas those for Mollar de Elche are 38.60 and 45.40 mm, respectively, and both are in the stage I:71.
In the second decade of July, the value for the Wonderful is 66.71 mm width in contrast to 52.19 mm for Mollar de Elche. Notwithstanding, this indicates that the fruit of the two cv. have grown almost identically, respectively 13.72 and 13.59 mm.
During the first ten days of August, Wonderful grew in width by 4.98 mm and in height by 4.69 mm, and those of Mollar de Elche grew by 8.93 and 7.12 mm, respectively. This difference emphasizes the different phenological phases of the two cultivars: cv. Wonderful is in the second germination phase (K:39) and cv. Mollar de Elche is in the previous phase, which is the growth of the fruit (J:73); for cv. Wonderful in this phase continues until the second decade of August.
In August, there was a slowdown in fruit growth for both cultivars, which is graphically reflected in the inflection of the characteristic curve (Figure 7)—a trend certainly influenced by high temperatures [50]. The slowdown in growth continued until the first decade of September, although the two varieties were at the stage of ripeness of the fruit (L:81,85); in fact, in the second decade, the growth of cv. Mollar de Elche is 7.36 mm, and it is 10.19 mm in cv. Wonderful. This increase in growth is certainly favored by the increase in irrigation volumes, which are used to facilitate the rapid growth of the fruit.
During the whole period of the study, the relative growth rate (RGR) of the two diameters of the fruit showed a very similar trend in both cultivars. A peak in the percentage of growth rate can be seen in the first period of fruit growth, which is then followed by a strong decrease that can be attributed to the rise in the temperatures, as shown in Figure 1.
Then, following the beginning of irrigation in the second half of August, the RGR values go back to average values between 10 and 15%, until fruit reach their final dimensions. It is interesting to notice how, despite cv. Mollar de Elche being the smallest variety, RGR values reach a higher peak (35%) in this cv., while the peak of relative growth for cv. Wonderful is 26%.
The SI (%) of the two cultivars shows that the young fruit (phenological stage I:71) of both cultivars has a slightly elongated shape. Fruit of the cv. Wonderful later assume an almost perfect spherical shape until the end of its growth (phenological stages L:81, L:85), with an SI value of 0.987%, while fruit of the cv. Mollar de Elche appear to be slightly more swollen at the moment of the harvest with an SI of 0.931% (Figure 8).

Figure 8.
Shape index (%) of the fruit of the cultivar Wonderful (a) and Mollar de Elche (b), calculated as LD/TD. Data are expressed as mean values ± SD.
The volume (cm3) of the fruit showed a similar increase trend in the two cultivars during the observation period, and the fruit of the cv. Wonderful turned out to be the biggest ones with an average volume of 56.214 cm3 at the end of their growth, while the fruit of the cv. Mollar de Elche had a lower average volume of 37.991 cm 3 before harvest (Figure 9).

Figure 9.
Volume (cm3) of the fruit of the cultivar Wonderful (a) and Mollar de Elche (b). Data are expressed as mean values ± SD.
3.3. Physicochemical Analyses
Table 1 shows the external appearance characteristics of the fruit of the cv. Wonderful and cv. Mollar de Elche. During the development and ripening of the fruit of the Spanish cv. Mollar de Elche, the skin color changes ranging from green to greenish yellow and, finally, to brownish yellow with reddish spots (data not shown) [34]. Several studies on the cv. Wonderful cultivar have shown that the red pigmentation increases significantly during ripening [51].

Table 1.
External color characteristics of pomegranate fruit of cv. Wonderful and cv. Mollar de Elche. FCI: fruit color index; CC: percentage of cover color. Means with different letters are significantly different at p ≤ 0.05 using Tukey’s test. Letter “a” denotes the highest value.
The FCI is higher in cv. Wonderful, which indicates a more intense red color than cv. Mollar de Elche. Another important parameter is the percentage of CC (%). The consumer is more attracted to fruit with a more intense deep red tint and uniform CC [52,53].
The color characteristics of pomegranate cultivars also indicate the possibility of using these values as a ripening index and for the separation of the fruit into commercial categories [54].
Table 2 shows the skin characteristics of the two cv. analyzed. It is immediately noticeable that the fruit of the cv. Wonderful have a greater size and weight and can be classified in the UNECE (United Nations Economic Commission for Europe) category 1/A, while cv. Mollar de Elche fruit fall into category 2/B [52].

Table 2.
External characteristics of pomegranate fruit of the cv. Wonderful and cv. Mollar de Elche. FW: fruit weight SW: skin weight; ST: skin thickness; SkI: skin index; STI: skin thickness index. Means with different letters are significantly different at p ≤ 0.05 using Tukey’s test. Letter “a” denotes the highest value.
ST was 4.44 mm in cv. Wonderful and 4.24 mm in cv. Mollar de Elche. This parameter can be interesting for post-harvest management; in fact, a greater thickness of the skin decreases the transpiration of the fruit during storage [55].
SkI indicates the incidence of the skin on the total weight of the fruit and, it can be noticed that the cv. Mollar de Elche has a higher SkI than the cv. Wonderful. This parameter could be useful in order to be able to classify the fruit commercially, with particular importance in the processing sector, since, for the same weight of fruit, the market prefers fruit with the highest edible part yield [46]. In the cv. Mollar de Elche, both ST and STI values are similar to those determined by Hernández et al. [56].
The parameters measured on arils determine their economic value and thus represent important factors for growers, the market, and industry [56]. Table 3 and Table 4 show the quality characteristics respectively of the arils and seeds.

Table 3.
Quality characteristics of the arils of pomegranate fruit of the cv. Wonderful and cv. Mollar de Elche. NA: number of arils; WA: weight of arils per fruit; HA: height of arils; LA: length of arils; YA: yield of arils; ICA: color of arils; WA20: weight of 20 arils. Means with different letters are significantly different at p ≤ 0.05 using Tukey’s test. Letter “a” denotes the highest value.

Table 4.
Quality characteristics of pomegranate seeds of the cv. Wonderful and cv. Mollar de Elche: WPI: woody part index; SdW20: weight of 20 seeds. Means with different letters are significantly different at p ≤ 0.05 using Tukey’s test. Letter “a” denotes the highest value.
As regards arils (Table 3), NA varies considerably between the two cultivars, cv. Wonderful has the highest number of arils and a higher yield of arils (YA). This parameter indicates the incidence of the weight of arils on the fruit fresh weight: a higher yield in arils reflects in a better commercial quality of the fruit [50].
There is no correlation between skin color and aril color within the same fruit [31]; the two varieties reached a very high and similar value of ICA, demonstrating no significant difference for this parameter.
The WA20 is higher in cv. Mollar de Elche: this value is correlated to a higher HA and LA, which are values that are in agreement with the examinations carried out by Hernández et al. [56].
Seeds softness is a desirable economic trait that enhances the consumptive qualities of fruit [57], so WPI and SdW20 were measured on the fruit (Table 4). WPI is considered to be of minor importance in relation to the raw fiber content and firmness of the seed, but it gives a good idea of the low palatability of the seed because it refers to the quantity of ligneous material in relation to the total weight of the seed [58].
Both indices turned out to be smaller in the Mollar de Elche variety, and according to Mena et al. [59], this may make this variety more suitable for fresh consumption.
Table 5 shows all the physicochemical characteristics determined on the juice. JC (mL per 100 g) does not significantly vary between the two varieties. Both varieties have reported values that satisfy the requirements for the juice extraction industry. This parameter is of great interest for the industry, but also for the consumer, due to the nutraceutical value of the juice [23,60].

Table 5.
Characteristics of pomegranate juice of the cv. Wonderful and cv. Mollar de Elche. JC = juice content, TSS: soluble solids content; TA: titratable acidity. Means with different letters are significantly different at p ≤ 0.05 using Tukey’s test. Letter “a” denotes the highest value.
Melgarejo et al. [22] classified pomegranate cultivars into three levels of sweetness, depending on their soluble solids content (TSS) and titratable acidity (TA): the varieties were divided into “sweet” (TSS levels above 13 and TA below 0.7%), “sweet and acid” (TSS 12–13% and TA 0.7–1.8%), and “acid” (TSS below 12% and TA above 1.8%). According to Chace et al. [61], in fact, pomegranates are appropriate for the fresh market when their acidity content is less than 1.8%. These values are not stable but vary during maturation and the post-harvest phase [22].
As for the TSS content of the juice, the two cv. do not differ significantly: in cv. Wonderful, this parameter scored 16.74 °Brix, and 16.14 °Brix in the cv. Mollar de Elche, which are values that are in line with the work of Andreu-Sevilla et al. [62]. We can say that based on the physical and chemical characteristics present in the juice, the cultivar Mollar de Elche is more oriented toward the production of juices, and as confirmed by other studies [59].
Another important characteristic to take into account in pomegranate is the ratio of TSS/TA [63], which is a more reliable indicator of taste, quality, and ripeness than TSS alone. In cv. Mollar de Elche, the TSS/TA ratio has a value of 16.14—higher than cv. Wonderful, which has a value of 11.16. This parameter is also used as a destructive index to assess the degree of ripeness of the fruit and, therefore, the optimal time for harvesting.
To date, the following classification has been used for Spanish varieties based on TSS/TA value [12]: sweet varieties: 31–98; sweet–sour varieties: 17–24; acid varieties: 5–7. Both varieties, according to the above classification, fall between the groups of sweet–sour and acid varieties. However, referring to the Melgarejo classification [12], the fruit of both cultivars are identified as sweet–sour.
3.4. Sensory Analysis
Figure 10a shows the results of the sensory analysis on arils. The descriptors that reported statistically significant differences are color, sweet, acid, and astringent. The judgment on the color of the arils was significantly higher in cv. Wonderful (8.22) than in the cv. Mollar de Elche (4.22), indicating a more intense coloring in the first cultivar. These sensory results are confirmed by colorimetric analyses, where cv. Mollar de Elche reported values lower than cv. Wonderful.

Figure 10.
Sensory profile of the arils (a) and juice (b) of the pomegranate fruit cv. Wonderful and cv. Mollar de Elche. For each descriptor, the values marked with * indicate significant differences between treatments.
Both the sweet and the acidic descriptor confirmed cv. Wonderful as the less sugary variety; in fact, the judges assigned values of 6.77 for the descriptor sweet and 2.44 for the descriptor acid in the cv. Mollar de Elche, and 3.22 for the descriptor sweet and 5.33 for descriptor acid in cv. Wonderful. This is in line with the TSS and TA values found and their ratio, which would indicate cv. Mollar de Elche as the sweetest.
It should be noticed that sweet varieties are certainly more appreciated for fresh consumption [10,58]. Descriptor astringency was higher in cv. Wonderful (6.00), while it was statistically lower in cv. Mollar de Elche (2.66).
Although the arils in the overall evaluation reached a score of 5.77 for cv. Wonderful and 6.55 for cv. Mollar de Elche, the differences are not statistically significant. Considering the significant descriptors, we were able to identify in cv. Mollar de Elche a higher suitability for fresh consumption, due to the higher value of sweetness, pomegranate odor, but also a lower sensation of acidity and astringency. The cv. Wonderful, with its high color intensity and lower pH value, seems to be more suitable for use as fresh-cut product [10].
Figure 10b shows the sensory analysis on aril juice. The descriptors that showed statistically significant differences are color, herbaceous odor, sweet, acid and astringent. The juice color was assessed higher for the cv. Wonderful (7.66) than for the cv. Mollar de Elche (5.88). Similar values were found by Andreu-Sevilla et al. [62] who, comparing the pomegranate juice and the wine obtained from it, stated that a positive aspect of the Wonderful variety was its intense red color, which led to an intense color of the wine, while cv. Mollar de Elche had a juice with a color intensity of 3.5 ± 0.3. In addition, the herbaceous odor descriptor, which is usually linked to a more backward stage of maturation, is unfavorable in the cv. Wonderful because it is more perceived by the judges than in the cv. Mollar de Elche.
The descriptor sweetness score was lower in Wonderful (3.11) and higher in Mollar de Elche (7.66). For the acid descriptor, the scores confirm the results from the physicochemical analyses. The juice of the cv. Mollar de Elche, due to its lower acidity and pH and higher TSS content, is more suitable for immediate consumption; in fact, consumers prefer sweeter flavors to acidic ones [10]. The data obtained coincide with the results of Andreu-Sevilla et al. [62], who defines the juice of the cv. Wonderful as acid, astringent, with notes of vinegar and only slightly sweet, while the juice of the cv. Mollar de Elche is described as sweet, acid, and only slightly astringent.
The overall score also differs statistically significantly between the two cultivars, due to the lower acidity and pH value of the cv. Mollar de Elche and the higher TSS content. Wonderful cv. gets a score of 4.77, while cv. Mollar de Elche gets a score of 7.00.
Therefore, from the results obtained, we can conclude that the juice of the cv. Mollar de Elche is much sweeter, less acidic, and astringent, which are properties that allow a greater appreciation by the consumer, who could use this fruit to obtain juices to be consumed in a short time. On the other hand, Wonderful cv. shows less sweetness, greater acidity, astringency, and a much higher intensity than the red color, which suggests a variety that is more suitable for industrial use.
4. Discussion
In this work, we showed that cv. Mollar de Elche can be considered an early variety compared to the market standard cv. Wonderful, as ripening and harvesting took place in the first ten days of October. The growth of the fruit was influenced by the high temperatures of the summer months, which made it essential to use basic irrigation, especially during the fruit’s swelling period (from the end of August to the beginning of October) to support the processes of accumulation of bioactive connections and obtain high-quality fruit.
The results of pomological and internal physicochemical composition analyses confirm that it is possible, in Sicily, to obtain quality characteristics equal to those demonstrated by studies carried out on Wonderful and Mollar de Elche varieties in other suitable environments.
The fruit of the cv. Wonderful, with a more intense color and a homogeneous cover color, would seem to capture the consumer’s attention more. However, the physicochemical properties of the juice indicate a good propensity to industrial production and to the marketing of the arils as fresh cut product. Mollar de Elche cv., with smaller size and less intense coloring is less attractive to the consumer, although the lower woody part index and the high TSS/TA ratio make it suitable to meet the consumer’s needs for fresh fruit.
However, the results on the pomological characteristics and chemical composition of the varieties Wonderful and Mollar de Elche do not exclude the possibility that the two cultivars may be used for both fresh and processed fruit.
Sensory evaluations, on the other hand, while confirming the data from physicochemical analyses, seem to define more precisely the attitudes of both varieties. The juice of the cv. Wonderful has a stronger color, acidity, astringency, and herbaceous odor than the cv. Mollar de Elche, which are properties that make it preferable for juice production. Mollar de Elche’s arils scored higher in the descriptors of the sweet, and lower in those of bitter, astringency, which are the properties that most affect the consumer of fresh fruit.
Further research should be carried out in order to better assess the cultivation of pomegranate in Sicily from a vegetative-productive and qualitative point of view. This would enable growers to better understand the influence of climatic factors during fruit development and ripening in order to improve the organoleptic and commercial quality of the fruit.
The results of this study on plant phenology, fruit growth, physicochemical characteristics, and sensory properties, which diversify the two cultivars, allowed us to identify the greatest potential of their cultivation in a Mediterranean climate, their influence on the market, and appreciation by the pomegranate consumer.
Author Contributions
Conceptualization, V.F. and A.M.; methodology, V.F., and A.M.; validation, I.T., D.S., G.S., A.M. and V.F.; formal analysis, I.T., and D.S.; resources: G.S., investigation, A.M., and G.S.; data curation, I.T., and D.S.; writing—original draft preparation, I.T., D.S. and G.S.; writing—review and editing, I.T., D.S. and V.F.; supervision, V.F. All authors have read and agreed to the published version of the manuscript.
Funding
This research received no external funding.
Institutional Review Board Statement
Not applicable.
Informed Consent Statement
Not applicable.
Data Availability Statement
The data presented in this study are available on request from the corresponding author. The data are not publicly available due to privacy policy of the Authors’ Institution.
Acknowledgments
The authors wish to thank SIAS—Servizio Informativo Agrometeorologico Siciliano for providing climatic and meteorological data, the Gibiino Farm for plant materials and Calogero Natalello who discussed this work as his graduation thesis.
Conflicts of Interest
The authors declare no conflict of interest.
References
- Preece, J.E.; Moersfelder, J. Pomegranate: The grainy apple. J. Am. Pomol. Soc. 2016, 70, 187–193. [Google Scholar]
- Chater, J.M.; Merhaut, D.J.; Jia, Z.; Mauk, P.A.; Preece, J.E. Fruit quality traits of ten California-grown pomegranate cultivars harvested over three months. Sci. Hortic. 2018, 237, 11–19. [Google Scholar] [CrossRef]
- Morton, J.F. Fruits of Warm Climates; Creative Resource Systems, Inc.: Winterville, NC, USA, 1987; ISBN ISBN 0-9610184-1-0. Available online: https://hort.purdue.edu/newcrop/morton/index.html (accessed on 15 January 2021).
- Jbir, R.; Hasnaoui, N.; Mars, M.; Marrakchi, M.; Trifi, M. Characterization of Tunisian pomegranate (Punica granatum L.) cultivars using amplified fragment length polymorphism analysis. Sci. Hortic. 2008, 115, 231–237. [Google Scholar] [CrossRef]
- Melgarejo, P.; Martínez, J.; Hernández, F.; Martínez, R.; Legua, P.; Oncina, R.; Martinez-Murcia, A. Cultivar identification using 18S–28S rDNA intergenic spacer-RFLP in pomegranate (Punica granatum L.). Sci. Hortic. 2009, 120, 500–503. [Google Scholar] [CrossRef]
- Levin, G.M. Pomegranate; Turkmen Experimental Station of Genetic Resources of Plants: Kara-Kala, Turkmenistan, 2006; ISBN 1-932657-73-8. [Google Scholar]
- Kader, A.A.; Chordas, A.; Elyatem, S. Responses of pomegranates to ethylene treatment and storage temperature. Calif. Agric. 1984, 38, 14–15. [Google Scholar]
- Cristosto, C.; Mitcham, E.; Kader, A. Pomegranate: Recommendations for maintaining postharvest quality. Prod. Facts Postharvest Res. Inf. Cent. Univ. Calif. Davis USA. Available online: http://postharvest.ucdavis.edu/files/259437.pdf (accessed on 13 December 2020).
- Al-Said, F.; Opara, L.; Al-Yahyai, R. Physico-chemical and textural quality attributes of pomegranate cultivars (Punica granatum L.) grown in the Sultanate of Oman. J. Food Eng. 2009, 90, 129–134. [Google Scholar] [CrossRef]
- Mayuoni-Kirshenbaum, L.; Bar-Ya’akov, I.; Hatib, K.; Holland, D.; Porat, R. Genetic diversity and sensory preference in pomegranate fruits. Fruits 2013, 68, 517–524. [Google Scholar] [CrossRef]
- Martínez, J.J.; Melgarejo, P.; Hernández, F.; Salazar, D.M.; Martínez, R. Seed characterisation of five new pomegranate (Punica granatum L.) varieties. Sci. Hortic. 2006, 110, 241–246. [Google Scholar] [CrossRef]
- Melgarejo, P.; Martínez, R. El Granado; Ediciones Mundi-Prensa: Madrid, Spain, 1992; p. 163. [Google Scholar]
- Melgarejo, P.; Salazar, D. Tratado de Fruticultura Para Zonas Aridas; Ediciones Mundi-Prensa: Madrid, Spain, 2002; Volume II. [Google Scholar]
- Todaro, A.; Cavallaro, R.; MALFA, S.; Continella, A.; Gentile, A.; Fischer, U.; Carle, R.; Spagna, G. Anthocyanin profile and antioxidant activity of freshly squeezed pomegranate (Punica granatum L.) Juices of sicilian and spanish provenances. Ital. J. Food Sci. 2016, 28, 464–479. [Google Scholar]
- Aviram, M.; Dornfeld, L.; Rosenblat, M.; Volkova, N.; Kaplan, M.; Coleman, R.; Hayek, T.; Presser, D.; Fuhrman, B. Pomegranate juice consumption reduces oxidative stress, atherogenic modifications to LDL, and platelet aggregation: Studies in humans and in atherosclerotic apolipoprotein E–deficient mice. Am. J. Clin. Nutr. 2000, 71, 1062–1076. [Google Scholar]
- De Nigris, F.; Williams-Ignarro, S.; Lerman, L.O.; Crimi, E.; Botti, C.; Mansueto, G.; D’Armiento, F.P.; De Rosa, G.; Sica, V.; Ignarro, L.J. Beneficial effects of pomegranate juice on oxidation-sensitive genes and endothelial nitric oxide synthase activity at sites of perturbed shear stress. Proc. Natl. Acad. Sci. USA 2005, 102, 4896–4901. [Google Scholar] [CrossRef] [PubMed]
- Gil, M.I.; Tomás-Barberán, F.A.; Hess-Pierce, B.; Holcroft, D.M.; Kader, A.A. Antioxidant activity of pomegranate juice and its relationship with phenolic composition and processing. J. Agric. Food Chem. 2000, 48, 4581–4589. [Google Scholar] [CrossRef] [PubMed]
- Poyrazoğlu, E.; Gökmen, V.; Artιk, N. Organic acids and phenolic compounds in pomegranates (Punica granatum L.) grown in Turkey. J. Food Compos. Anal. 2002, 15, 567–575. [Google Scholar] [CrossRef]
- Seeram, N.P.; Adams, L.S.; Henning, S.M.; Niu, Y.; Zhang, Y.; Nair, M.G.; Heber, D. In vitro antiproliferative, apoptotic and antioxidant activities of punicalagin, ellagic acid and a total pomegranate tannin extract are enhanced in combination with other polyphenols as found in pomegranate juice. J. Nutr. Biochem. 2005, 16, 360–367. [Google Scholar] [CrossRef]
- Passafiume, R.; Perrone, A.; Sortino, G.; Gianguzzi, G.; Saletta, F.; Gentile, C.; Farina, V. Chemical–physical characteristics, polyphenolic content and total antioxidant activity of three Italian-grown pomegranate cultivars. NFS J. 2019, 16, 9–14. [Google Scholar] [CrossRef]
- Fadavi, A.; Barzegar, M.; Azizi, M.; Bayat, M. Note. Physicochemical composition of ten pomegranate cultivars (Punica granatum L.) grown in Iran. Food Sci. Technol. Int. 2005, 11, 113–119. [Google Scholar] [CrossRef]
- Melgarejo, P.; Salazar, D.M.; Artes, F. Organic acids and sugars composition of harvested pomegranate fruits. Eur. Food Res. Technol. 2000, 211, 185–190. [Google Scholar] [CrossRef]
- Al-Maiman, S.A.; Ahmad, D. Changes in physical and chemical properties during pomegranate (Punica granatum L.) fruit maturation. Food Chem. 2002, 76, 437–441. [Google Scholar] [CrossRef]
- Adiletta, G.; Petriccione, M.; Liguori, L.; Pizzolongo, F.; Romano, R.; Di Matteo, M. Study of pomological traits and physico-chemical quality of pomegranate (Punica granatum L.) genotypes grown in Italy. Eur. Food Res. Technol. 2018, 244, 1427–1438. [Google Scholar] [CrossRef]
- Viuda-Martos, M.; Fernández-López, J.; Pérez-Álvarez, J. Pomegranate and its many functional components as related to human health: A review. Compr. Rev. Food Sci. Food Saf. 2010, 9, 635–654. [Google Scholar] [CrossRef]
- Barone, E.; Caruso, T.; Marra, F.P.; Sottile, F. Pomegranate (Punica granatum L.) Varieties. J. Am. Pomol. Soc. 2001, 55, 4–7. [Google Scholar]
- Damigella, P. Pomegranate cultivation in eastern Sicily. Tec. Agric. 1960, 12, 591–605. [Google Scholar]
- La Malfa, S.; Gentile, A.; Domina, F.; Tribulato, E. Primosole: A New Selection from Sicilian Pomegranate germplasm. Acta Hortic. 2009, 818, 125–132. [Google Scholar] [CrossRef]
- Adiletta, G.; Liguori, L.; Albanese, D.; Russo, P.; Di Matteo, M.; Crescitelli, A. Soft-seeded pomegranate (Punica granatum L.) varieties: Preliminary characterization and quality changes of minimally processed arils during storage. Food Bioprocess Technol. 2017, 10, 1631–1641. [Google Scholar] [CrossRef]
- Defilippi, B.G.; Whitaker, B.D.; Hess-Pierce, B.M.; Kader, A.A. Development and control of scald on wonderful pomegranates during long-term storage. Postharvest Biol. Technol. 2006, 41, 234–243. [Google Scholar] [CrossRef]
- Holland, D.; Hatib, K.; Bar-Ya’akov, I. Pomegranate: Botany, Horticulture, Breeding. In Horticultural Reviews; Janick, J., Ed.; John Wiley & Sons, Inc.: Hoboken, NJ, USA, 2009; pp. 127–191. ISBN 978-0-470-59377-6. [Google Scholar]
- Melgarejo Moreno, P. Arboricoltura: II melograno. Inf. Agrar. 1999, 55, 37–41. [Google Scholar]
- Cano-Lamadrid, M.; Lech, K.; Michalska, A.; Wasilewska, M.; Figiel, A.; Wojdyło, A.; Carbonell-Barrachina, Á.A. Influence of osmotic dehydration pre-treatment and combined drying method on physico-chemical and sensory properties of pomegranate arils, cultivar Mollar de Elche. Food Chem. 2017, 232, 306–315. [Google Scholar] [CrossRef]
- Melgarejo, P.; Martínez-Valero, R.; Guillamón, J.; Amorós, M.M.A. Phenological stages of the pomegranate tree (Punka granatum L.). Ann. Appl. Biol. 1997, 130, 135–140. [Google Scholar] [CrossRef]
- Ikinci, A.; Mamay, M.; Unlu, L.; Bolat, I.; Ercisli, S. Determination of heat requirements and effective heat summations of some pomegranate cultivars grown in Southern Anatolia. Erwerbs-Obstbau 2014, 56, 131–138. [Google Scholar] [CrossRef]
- Bleiholder, H.; van den Boom, J.; Langelüddeke, P.; Stauss, R. Einkeitliche Codierung der phänologischen Stadien bei Kultur-und Schadpflanzen. Gesunde Pflanz. 1989, 41, 381–384. [Google Scholar]
- Gianguzzi, L.; Papini, F.; Cusimano, D. Phytosociological survey vegetation map of Sicily (Mediterranean region). J. Maps 2016, 12, 845–851. [Google Scholar] [CrossRef]
- Ben-Arie, R.; Segal, N.; Guelfat-Reich, S. The maturation and ripening of the «Wonderful» pomegranate. J. Am. Soc. Hortic. Sci. 1984, 109, 898–902. [Google Scholar]
- Al-Yahyai, R.; Al-Said, F.; Opara, L. Fruit growth characteristics of four pomegranate cultivars from northern Oman. Fruits 2009, 64, 335–341. [Google Scholar] [CrossRef]
- Singh, K.K.; Reddy, B.S. Post-harvest physico-mechanical properties of orange peel and fruit. J. Food Eng. 2006, 73, 112–120. [Google Scholar] [CrossRef]
- Farina, V.; Lo Bianco, R.; Mazzaglia, A. Evaluation of late-maturing peach and nectarine fruit quality by chemical, physical, and sensory determinations. Agriculture 2019, 9, 189. [Google Scholar] [CrossRef]
- Mazzaglia, A.; Lanza, C.; Farina, V.; Barone, F. Evaluation of Fruit Quality in Loquat Using both Chemical and Sensory Analyses. III Int. Symp. Loquat 2010, 345–349. [Google Scholar] [CrossRef]
- Farina, V.; Volpe, G.; Mazzaglia, A.; Lanza, C. Fruit quality traits of two apricot cultivars. Acta Hortic. 2010, 862, 593–598. [Google Scholar] [CrossRef]
- Sortino, G.; Saletta, F.; Puccio, S.; Scuderi, D.; Allegra, A.; Inglese, P.; Farina, V. Extending the shelf life of white peach fruit with 1-methylcyclopropene and aloe arborescens edible coating. Agriculture 2020, 10, 151. [Google Scholar] [CrossRef]
- Sortino, G.; Allegra, A.; Farina, V.; Inglese, P. Postharvest quality and sensory attributes of ‘Pesca di Bivona’peaches (Prunus persica L.) during storage. Bulg. J. Agric. Sci. 2017, 23, 939–946. [Google Scholar]
- Pagliarini, E. Valutazione Sensoriale: Aspetti Teorici, Pratici e Metodologici; Hoepli: Milan, Italy, 2002; ISBN 88-203-3012-1. [Google Scholar]
- Torrecillas, A.; Domingo, R.; Galego, R.; Ruiz-Sánchez, M.C. Apricot tree response to withholding irrigation at different phenological periods. Sci. Hortic. 2000, 85, 201–215. [Google Scholar] [CrossRef]
- Pérez-Pastor, A.; Ruiz-Sánchez, M.C.; Martínez, J.A.; Nortes, P.A.; Artés, F.; Domingo, R. Effect of deficit irrigation on apricot fruit quality at harvest and during storage. J. Sci. Food Agric. 2007, 87, 2409–2415. [Google Scholar] [CrossRef]
- Gozlekci, S.; Kaynak, L. Physical and chemical changes during fruit development and flowering in pomegranate (Punica granatum L.) cultivar Hicaznar grown in Antalya region. Options Méditerranéennes Sér. Sémin. Méditerranéens 2000, 42, 79–85. [Google Scholar]
- Shulman, Y.; Fainberstein, L.; Lavee, S. Pomegranate fruit development and maturation. J. Hortic. Sci. 1984, 59, 265–274. [Google Scholar] [CrossRef]
- Shwartz, E.; Glazer, I.; Bar-Ya’akov, I.; Matityahu, I.; Bar-Ilan, I.; Holland, D.; Amir, R. Changes in chemical constituents during the maturation and ripening of two commercially important pomegranate accessions. Food Chem. 2009, 115, 965–973. [Google Scholar] [CrossRef]
- CBI. Exporting Fresh Pomegranates to Europe. 2019. Available online: https://www.cbi.eu/market-information/fresh-fruit-vegetables/pomegranates/europe (accessed on 16 December 2020).
- Al Said, F.; Al-Yahyai, R.; Opara, U. Traditional Cultivation of Pomegranate in Oman. II All Afr. Hortic. Congr. 2012, 549–555. [Google Scholar] [CrossRef]
- Kader, A.A. Postharvest Technology of Horticultural Crops; University of California Agriculture and Natural Resources: Davis, CA, USA, 2002; Volume 3311, ISBN 1-879906-51-1. [Google Scholar]
- Pieniazek, S. Physical characters of the skin in relation to apple fruit transpiration. Plant Physiol. 1944, 19, 529. [Google Scholar] [CrossRef]
- Hernández, F.; Legua, P.; Martínez, R.; Melgarejo, P.; Martínez, J.J. Fruit quality characterization of seven pomegranate accessions (Punica granatum L.) grown in Southeast of Spain. Sci. Hortic. 2014, 175, 174–180. [Google Scholar] [CrossRef]
- Zhang, X.; Zhao, Y.; Ren, Y.; Wang, Y.; Yuan, Z. Fruit breeding in regard to color and seed hardness: A genomic view from pomegranate. Agronomy 2020, 10, 991. [Google Scholar] [CrossRef]
- Melgarejo, P.; Calín-Sánchez, Á.; Vázquez-Araújo, L.; Hernández, F.; Martínez, J.J.; Legua, P.; Carbonell-Barrachina, Á.A. Volatile composition of pomegranates from 9 Spanish cultivars using headspace solid phase microextraction. J. Food Sci. 2011, 76, S114–S120. [Google Scholar] [CrossRef]
- Mena, P.; García-Viguera, C.; Navarro-Rico, J.; Moreno, D.A.; Bartual, J.; Saura, D.; Martí, N. Phytochemical characterisation for industrial use of pomegranate (Punica granatum L.) cultivars grown in Spain. J. Sci. Food Agric. 2011, 91, 1893–1906. [Google Scholar] [CrossRef]
- Tehranifar, A.; Zarei, M.; Nemati, Z.; Esfandiyari, B.; Vazifeshenas, M.R. Investigation of physico-chemical properties and antioxidant activity of twenty Iranian pomegranate (Punica granatum L.) cultivars. Sci. Hortic. 2010, 126, 180–185. [Google Scholar] [CrossRef]
- Chace, E.M.; Church, C.G.; Poore, H.D. The Wonderful Variety of Pomegranate; Contributions from Bureau of Chemistry and Soils; U.S. Dept. of Agriculture: Washington, DC, USA, 1930; p. 15.
- Andreu-Sevilla, A.J.; Mena, P.; Martí, N.; Viguera, C.G.; Carbonell-Barrachina, Á.A. Volatile composition and descriptive sensory analysis of pomegranate juice and wine. Food Res. Int. 2013, 54, 246–254. [Google Scholar] [CrossRef]
- Fawole, O.A.; Opara, U.L. Changes in physical properties, chemical and elemental composition and antioxidant capacity of pomegranate (cv. Ruby) fruit at five maturity stages. Sci. Hortic. 2013, 150, 37–46. [Google Scholar] [CrossRef]
Publisher’s Note: MDPI stays neutral with regard to jurisdictional claims in published maps and institutional affiliations. |
© 2021 by the authors. Licensee MDPI, Basel, Switzerland. This article is an open access article distributed under the terms and conditions of the Creative Commons Attribution (CC BY) license (http://creativecommons.org/licenses/by/4.0/).